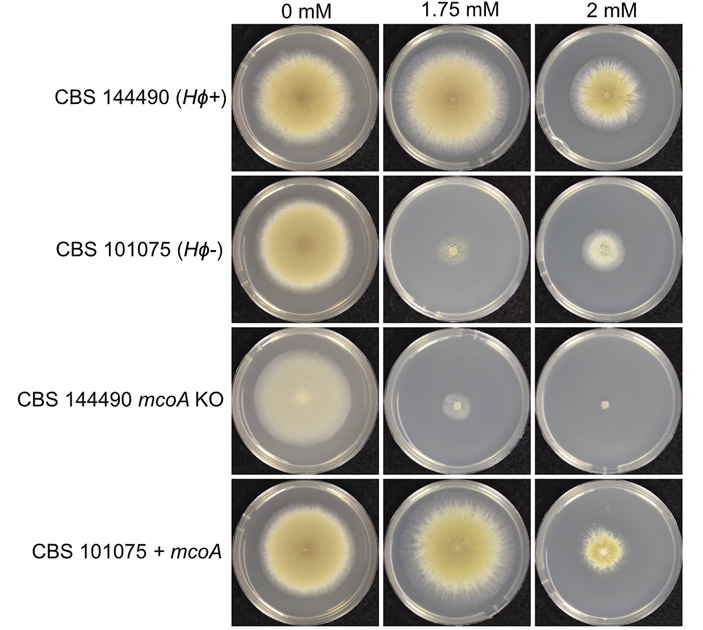
Рис. 3. Результаты эксперимента по проверке эффективности HEPHAESTUS в защите от металлов на примере меди

Транспозоны — это участки ДНК, которые могут перемещаться и размножаться в пределах генома. У разных организмов транспозоны занимают разную долю генетического кода (например, у людей на них приходится около 44% ДНК), но считается, что почти всегда они приходятся на некодирующую часть генома, — примеров однозначно полезных траспозонов ранее известно не было. Австралийские ученые сообщили об описании первого эукариотического транспозона, который облегчает адаптацию своего хозяина к окружающей среде. Этот транспозон, получивший говорящее название HEPHAESTUS, кодирует гены, продукты которых обеспечивают устойчивость к ряду ядовитых металлов и мышьяку у грибка Paecilomyces variotii и нескольких других видов грибков.
Горизонтальный перенос генов, то есть обмен генетическим материалом между организмами, не связанными отношениями «родитель — потомок», очень широко распространен в мире прокариот. Археи и бактерии с большой охотой обмениваются целыми кластерами генов, которые зачастую позволяют адаптироваться им к новым условиям среды — например, к появившемуся рядом антибиотику или другому токсичному веществу, которое необходимо нейтрализовать (см., например, новость Устойчивые к метициллину штаммы S. aureus были у ежей еще до открытия антибиотиков, «Элементы», 24.01.2022). Многие из таких полезных генных кластеров, обеспечивающих защиту от неблагоприятного фактора «под ключ», входят в состав мобильных генетических элементов — транспозонов, которые потом множатся в геномах своих хозяев.
Эукариотам (особенно микроскопическим) тоже бы пригодилась возможность обмена генетическим материалом с неродственными организмами — по тем же причинам: приобретение уже готового полезного гена может дать большое эволюционное преимущество. Однако эукариоты, как правило, уже не могут так легко и непринужденно обмениваться генами. Более того, до недавнего времени не было известно примеров транспозонов эукариот, которые напрямую приносили бы пользу своему хозяину. Но теперь такой пример есть: ученые из Австралии нашли в геноме грибка Paecilomyces variotii транспозон, который придает своему хозяину устойчивость к ионам ряда металлов. Авторы исследования назвали найденный транспозон HEPHAESTUS в честь Гефеста — древнегреческого бога, которого считали покровителем кузнецов.
Ионы тяжелых металлов (таких как кадмий и свинец) и металлоидов (например, мышьяка) чрезвычайно токсичны для живых клеток. Попадая в клетку, словно винт в часовой механизм, они повреждают биологические молекулы разной химической природы и нарушают ее функционирование. Некоторые металлы, например цинк и медь, в очень ограниченных количествах используются организмом как кофакторы некоторых белков, однако в высоких концентрациях они также токсичны для клеток. Несмотря на то, что грибы вообще часто накапливают ионы тяжелых металлов (именно поэтому грибы, собранные в экологически неблагоприятных районах — в городской черте, вдоль автотрасс и т. д. — опасно употреблять в пищу), металлы в больших концентрациях могут быть вредны и для них: некоторые содержащие медь соединения нашли применение в сельском хозяйстве в качестве эффективных фунгицидов.
Живые организмы (и грибы в частности) в ходе эволюции «разработали» несколько способов противостоять ядовитым ионам металлов и металлоидов: хелатирование токсичных ионов с помощью специальных белков (что позволяет изолировать их от остальных компонентов клетки), обезвреживание с помощью химических модификаций, наконец, клетки могут просто выкачивать металлы наружу или закачивать их в изолированные мембранные пузырьки — вакуоли. Например, дрожжи, использующиеся в виноделии, обладают белками, которые плотно связывают ионы меди. Благодаря этому виноделы могут обрабатывать виноградники от грибковых заболеваний медьсодержащими фунгицидами, не боясь навредить дрожжам.
Грибок Paecilomyces variotii, относящийся к аскомицетам, распространен повсеместно; он термоустойчив и может вызывать порчу продуктов, предварительно подвергнутых термической обработке. У людей с нарушениями иммунитета он может провоцировать микозы. Но в целом для неспециалиста это мало чем примечательный грибок.
Недавно были отсеквенированы геномы трех штаммов P. variotii. Сравнивания геномы разных штаммов, авторы обсуждаемой работы обнаружили, что у двух штаммов есть участок генома длиной примерно 85 тысяч пар оснований, которого нет у третьего штамма. Сравнение с последовательностями уже отсеквенированных генов из баз данных показало, что гены, наличие которых в этом участке генома удалось предсказать биоинформатическими методами, по-видимому, связаны с защитой от ядовитых металлов. Авторы расширили выборку и включили в анализ геномы еще 12 штаммов P. variotii на предмет наличия загадочного участка генома. Он нашелся в трех случаях, причем в каждом из них в состав HEPHAESTUS входили гены pcaA, mcoA и zrc1, связанные с детоксификацией ядовитых металлов. Что именно кодируют эти гены, мы расскажем чуть позже.
Наличие транспозона HEPHAESTUS у одних штаммов P. variotii и его отсутствие у других можно объяснить тем, что некоторые штаммы передавали эту последовательность друг другу в ходе горизонтального переноса генов, тем более что у нитчатых грибков, к которым относится и P. variotii, этот процесс вполне может происходить. Дополнительную информацию о природе этого транспозона и о возможностях его распространения среди грибов дал анализ концов его нуклеотидной последовательности. Оказалось, что во всех случаях по концам транспозона HEPHAESTUS располагаются инвертированные повторы (то есть с одной стороны последовательности повтор развернут в одну сторону, а с другой стороны — в противоположную), причем они оказались весьма консервативными, так как практически совпадали во всех случаях.
Наличие инвертированных повторов по концам — важный признак, который указывает на то, что данная последовательность нуклеотидов является мобильным генетическим элементом. Кроме того, в составе HEPHAESTUS был найден ген, кодирующий транспозазу (фермент, с помощью которого транспозон может путешествовать по геному), а также последовательность, кодирующую домен с функциональностью РНКазы H обратной транскриптазы, и ген hhpA, продукт которого, вероятно, является интегразой. Таким образом, HEPHAESTUS содержит полный арсенал генов, которые могут понадобиться для транспозиции (рис. 2). Наконец, сравнение его локации в геномах разных штаммов показало, что во всех случаях гены, окружающие этот участок, располагались в разных частях генома, при том, что порядок генов относительно друг друга у проанализированных штаммов грибка был одинаков. Таким образом, налицо факт интеграции HEPHAESTUS в разные места генома разных штаммов P. variotii.

Рис. 2. Транспозоны эукариот подразделяют на ретротранспозоны и ДНК-транспозоны. ДНК-транспозоны вырезаются из одного участка генома и вставляются в другой под действием фермента транспозазы. Характерный признак таких транспозонов — инвертированные повторы по краям (terminal inverted repeats, TIR). Ретротранспозоны перемещаются по геному через промежуточную стадию — РНК, которая затем переводится в ДНК обратной транскриптазой и встраивается в новый участок в геноме под действием фермента интегразы. По концам таких транспозонов находятся длинные концевые повторы (long terminal repeats, LTR), причем на обоих концах они развернуты в одну сторону. Рисунок с сайта onlinebiologynotes.com
P. variotii относится к порядку эуроциевые (Eurotiales). Оказалось, что HEPHAESTUS — не уникальная особенность P. variotii: похожие транспозоны были найдены и у шести других видов эуроциевых, причем располагались они в самых разных местах геномов. Во всех случаях последовательности предполагаемых транспозонов несли характерные концевые повторы, содержали ген hhpA ближе к началу и включали в себя кластер генов, обеспечивающих устойчивость к ядовитым металлам.
Выявление последовательностей, очень близких к HEPHAESTUS, у филогенетически далеких видов эуроциевых дополнительно укрепило гипотезу ученых о том, что он является транспозоном. Слишком уж близки последовательности копий HEPHAESTUS у далеких видов, даже в области псевдогенов — «поломанных» генов, на которые отбор почти не давит и которые при вертикальной передаче (от родителя к потомку) накапливают массу мутаций. Кроме того, одинаковые последовательности на концах свидетельствуют в пользу того, что HEPHAESTUS во всех случаях перемещается с помощью одного механизма (впрочем, какого именно, авторы исследования не уточняют).
Биоинформатические предсказания генов и их функций — это хорошо, но защищает ли HEPHAESTUS от токсического действия ионов металлов на самом деле? Самый простой способ проверить это — сравнить, как растут на среде, содержащей соли металлов, штаммы грибка, имеющие HEPHAESTUS или лишенные его (рис. 3). Результаты этих простейших экспериментов оказались не вполне однозначными. Скорость роста разных штаммов существенно отличалась сама по себе. Тем не менее, исследователи смогли убедительно показать, что четыре штамма, имеющих HEPHAESTUS, обладают повышенной устойчивостью к ионам цинка, кадмия, свинца и меди. С мышьяком ситуация была менее однозначная: различия в скорости роста удалось выявить, только если штаммы, несущие HEPHAESTUS или лишенные его, выращивали в жидкой, а не твердой среде, содержащей мышьяк.
Рис. 3. Результаты эксперимента по проверке эффективности HEPHAESTUS в защите от металлов на примере меди. Четыре штамма — несущий полный HEPHAESTUS; лишенный HEPHAESTUS целиком; несущий HEPHAESTUS, из которого был удален ген mcoA, кодирующий оксидазу меди; лишенный полного HEPHAESTUS, но имеющий ген mcoA — были высеяны на среды с возрастающей концентрацией меди. Как можно видеть, полная версия HEPHAESTUS дает возможность грибку расти даже при наличии в среде меди в концентрации 2 мМ. В составе HEPHAESTUS за устойчивость к меди отвечает ген mcoA, вставка которого в геном также позволяет грибку расти при высокой концентрации меди. Рисунок из обсуждаемой статьи в Current Biology
Чтобы окончательно доказать, что HEPHAESTUS отвечает за устойчивость к ионам ряда металлов и металлоидов, авторы работы провели классический генетический эксперимент: они скрестили два штамма, один из которых имел транспозон HEPHAESTUS, а другой — нет, и затем проверили, как его унаследовали потомки и насколько они были устойчивы к ионам металлов. Эксперимент показал, что этот транспозон действительно обеспечивает своему обладателю устойчивость к ионам цинка, кадмия, свинца, меди и мышьяка.
Чем же объясняются чудодейственные свойства этого транспозона? Как упоминалось выше, биоинформатический анализ позволил выявить в его составе три гена, связанных с защитой от металлов — pcaA, mcoA и zrcA. Ученые выяснили, что продуктом гена pcaA является АТФаза, которая откачивает из клетки ионы кадмия и свинца. Более того, появление этих ионов в среде активирует экспрессию pcaA. Продукт гена zrcA является транспортером, удаляющим из клетки избыток ионов цинка. Как и в случае с pcaA, повышенное содержание цинка в среде увеличивает экспрессию zrcA. За защиту от мышьяка отвечают несколько генов в составе HEPHAESTUS, в том числе arsH, arsC и arsB. Продукты этих генов обеспечивают слаженную детоксификацию мышьяка. Наконец, ген mcoA кодирует оксидазу меди.
Таким образом, транспозон HEPHAESTUS дает своему хозяину полный арсенал средств для защиты от ряда металлов и мышьяка. Вполне возможно, что обмен крупными генетическими конструкциями с помощью транспозонов у эукариот происходит гораздо чаще, чем мы думаем.
Источник: Andrew S. Urquhart, Nicholas F. Chong, Yongqing Yang, Alexander Idnurm. A large transposable element mediates metal resistance in the fungus Paecilomyces variotii // Current Biology. 2022. DOI: 10.1016/j.cub.2021.12.048.
Елизавета Минина




Рис. 1. Грибок Paecilomyces variotii. Слева — колонии, выросшие в чашке Петри за неделю, очень похожи на обычную плесень, которая то и дело вырастает на испорченных продуктах. Справа — микрофотография, на которой видны конидиеносцы с конидиями (грибок был предварительно окрашен), размер которых составляет 2–4 мкм. Фото с сайта thunderhouse4-yuri.blogspot.com